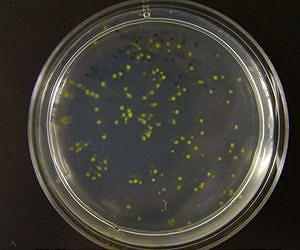

|

World's lightest material created
Chinese scientists say they have developed the world's lightest material, lighter than air, which could play an important role in tackling pollution. ... more
|  |

Raytheon helps MDA counter ballistic missile threat with delivery of 8th AN/TPY-2 radar
Raytheon has delivered its eighth AN/TPY-2 radar to the Missile Defense Agency (MDA) in support of the U.S. combatant commands. An integral capability of the Ballistic Missile Defense System (BMDS), ... more
|  |

Scripps scientists discover 'lubricant' for Earth's tectonic plates
Scientists at Scripps Institution of Oceanography at UC San Diego have found a layer of liquefied molten rock in Earth's mantle that may be acting as a lubricant for the sliding motions of the plane ... more
|  |

New Space Station Crew Members to Launch and Dock the Same Day
Three new crew members are set to launch to the International Space Station on a six-hour flight to travel from the launch pad to their destination. Chris Cassidy of NASA, along with Pavel Vinogrado ... more
|
Ocean plankton sponge up nearly twice the carbon currently assumed
Ocean plankton sponge up nearly twice the carbon currently assumed





